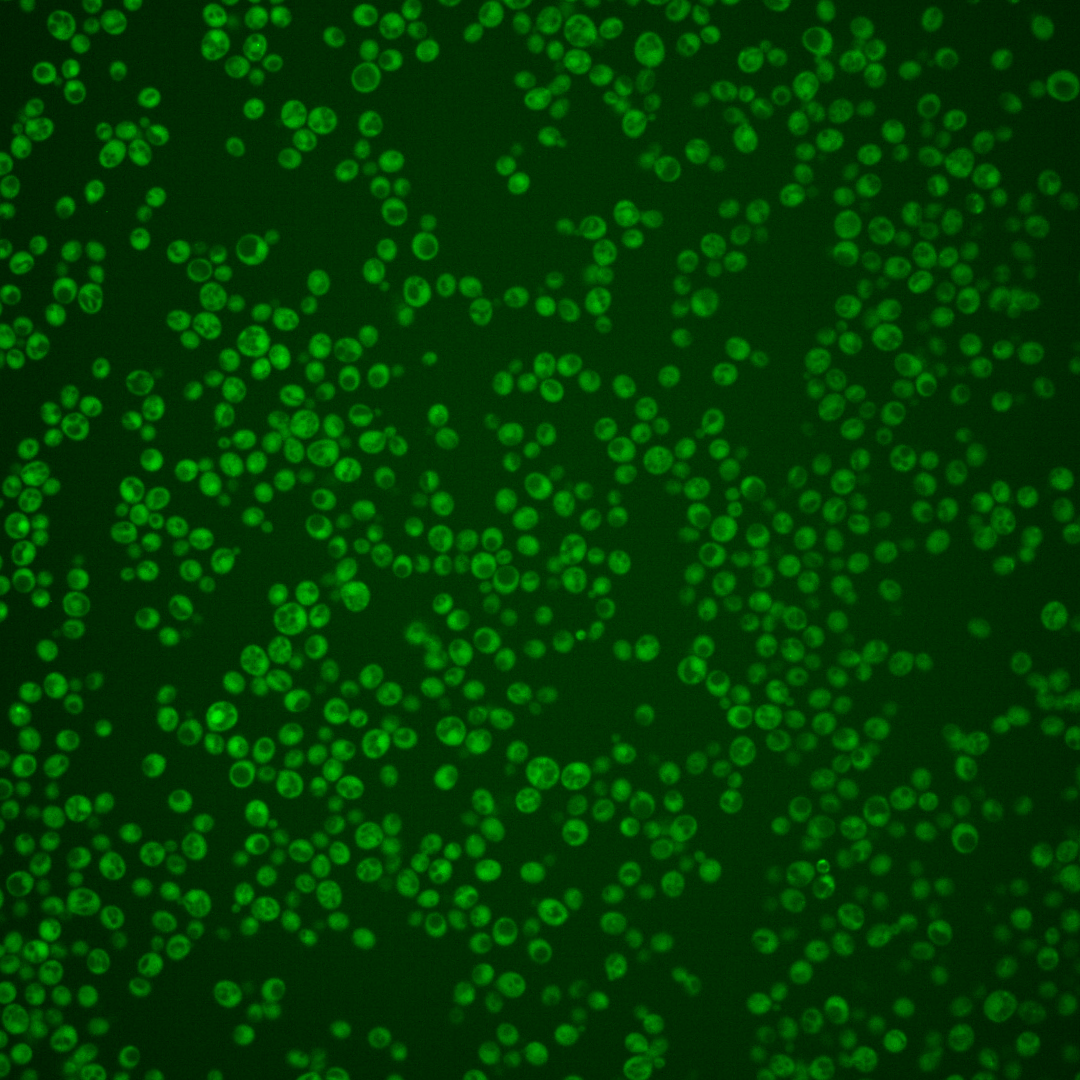
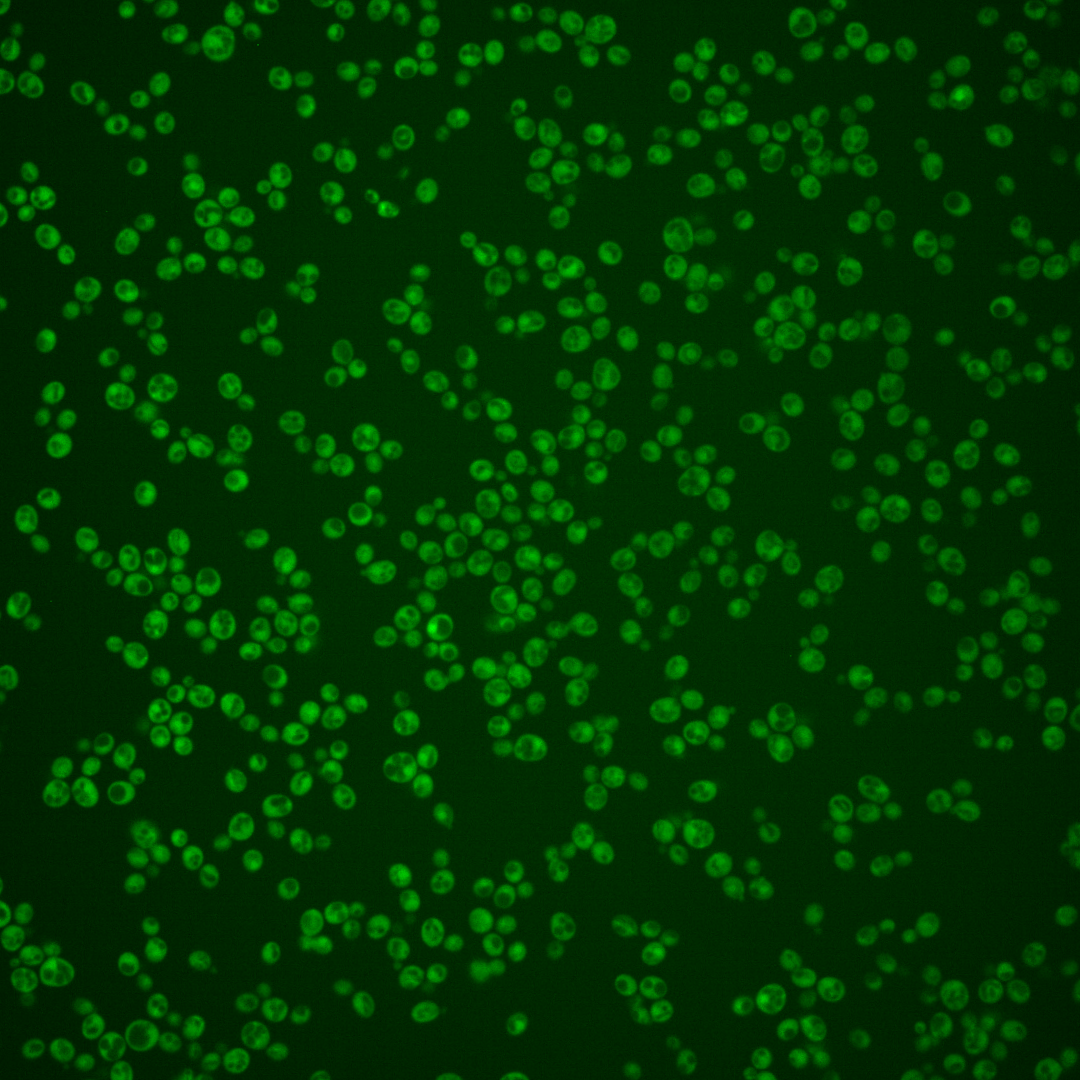
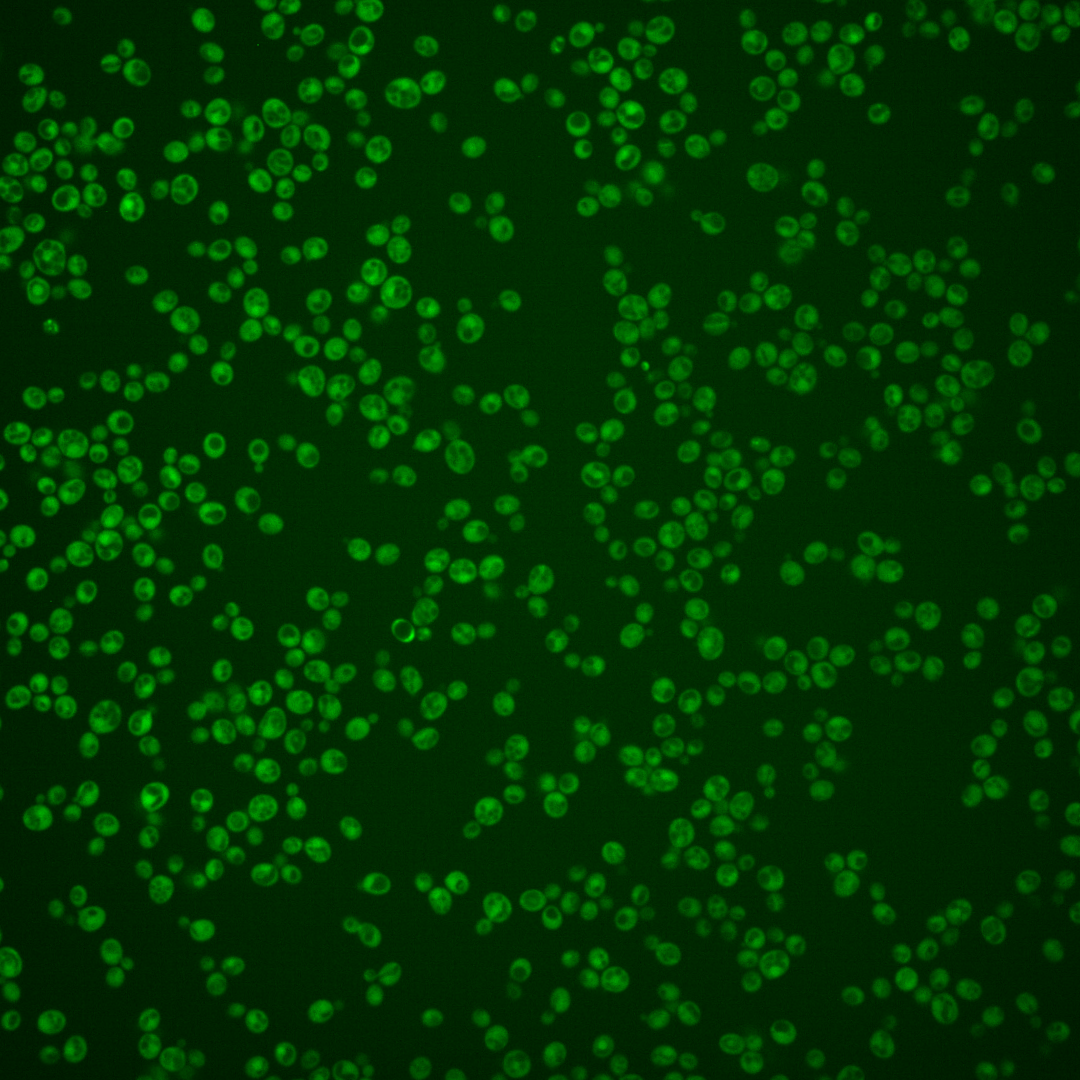
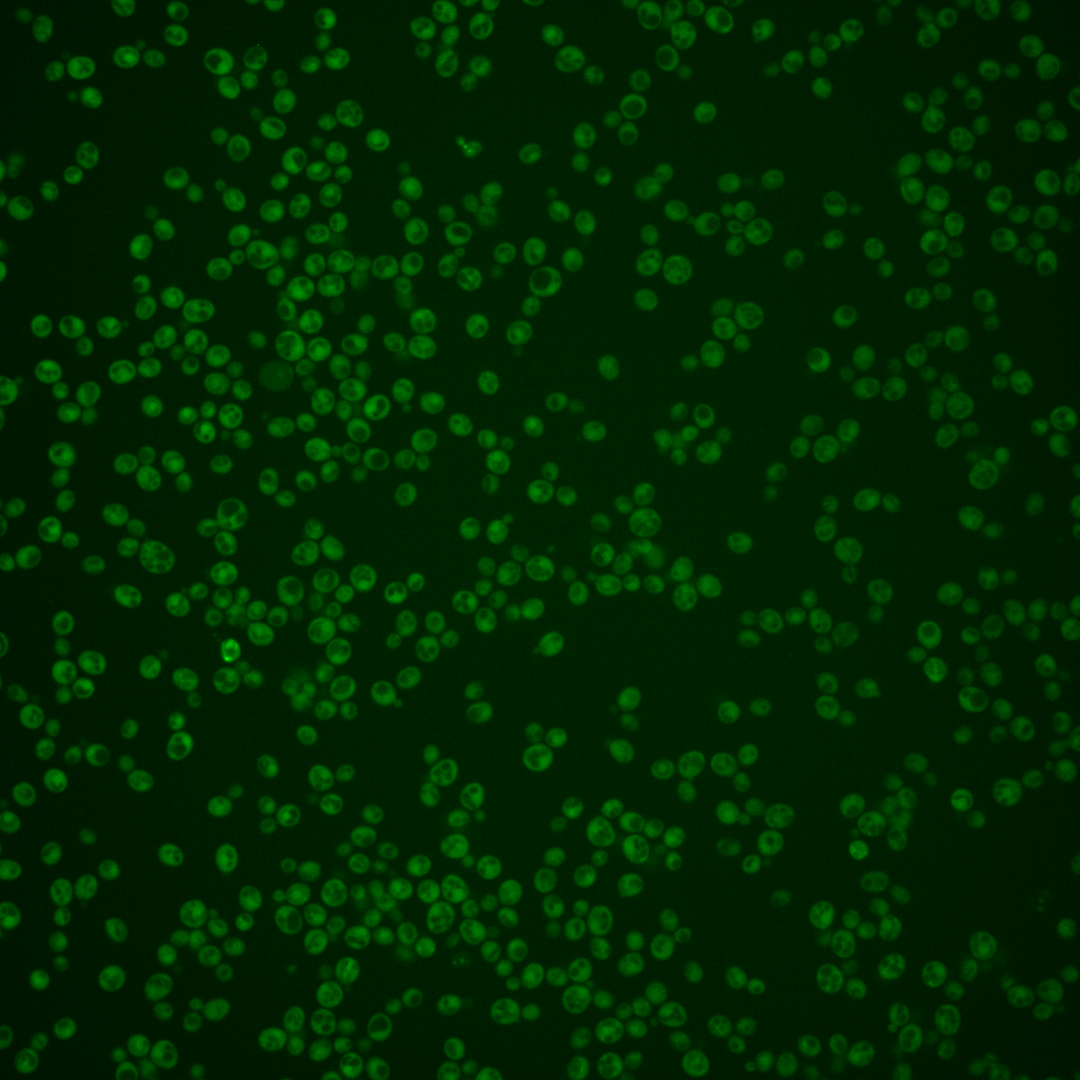
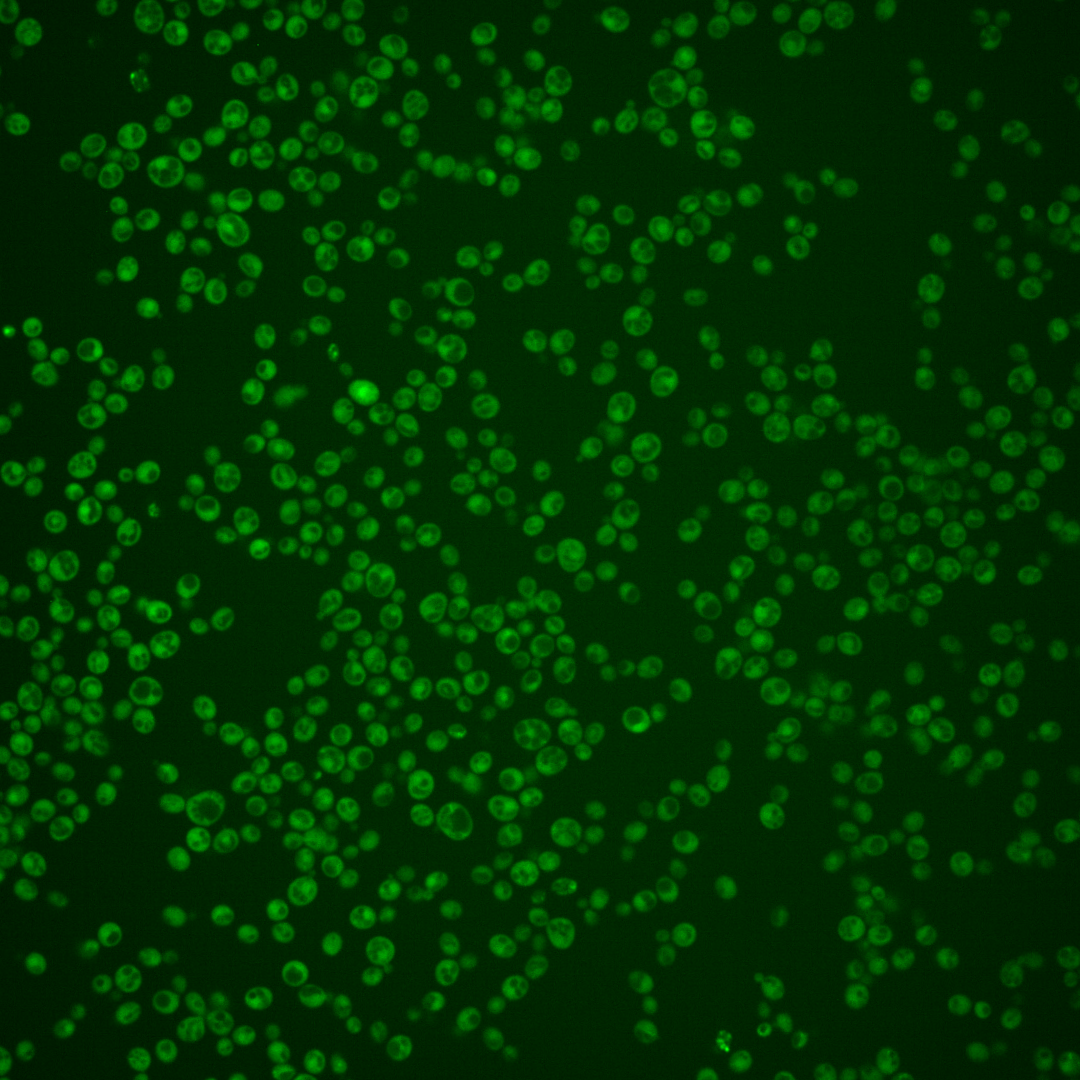

| Standard name | |
|---|---|
| Human Ortholog | |
| Description | S-adenosylmethionine-dependent methyltransferase; seven-beta-strand lysine methyltransferase which trimethylates translation elongation factor EF2 (Eft1p and Eft2p) at lysine 509; green fluorescent protein (GFP)-fusion protein localizes to the cytoplasm; ortholog of human gene FAM86A |
Micrographs




















































































Sub-cellular Localization
Yeast GFP Assignment
Protein Abundance
Localization Change
External localization resources
| ensLOC | DeepLoc | |||||||||||||||||||||||
|---|---|---|---|---|---|---|---|---|---|---|---|---|---|---|---|---|---|---|---|---|---|---|---|---|
| Localization | WT1 | WT2 | WT3 | RAP60 | RAP140 | RAP220 | RAP300 | RAP380 | RAP460 | RAP540 | RAP620 | RAP700 | HU80 | HU120 | HU160 | rpd3Δ_1 | rpd3Δ_2 | rpd3Δ_3 | WT1 | WT2 | WT3 | AF100 | AF140 | AF180 |
| Cortical Patches | 0 | 1 | 0 | 0 | 0 | 3 | 0 | 0 | 0 | 0 | 0 | 1 | 0 | 0 | 0 | 0 | 0 | 0 | 0 | 2 | 1 | 0 | 1 | 0 |
| Bud | 0 | 1 | 2 | 0 | 3 | 6 | 9 | 17 | 8 | 7 | 22 | 19 | 0 | 1 | 0 | 0 | 0 | 0 | 0 | 2 | 1 | 0 | 3 | 1 |
| Bud Neck | 0 | 0 | 0 | 0 | 1 | 0 | 0 | 0 | 0 | 0 | 0 | 0 | 0 | 0 | 0 | 0 | 0 | 0 | 2 | 0 | 1 | 0 | 0 | 2 |
| Bud Site | 0 | 0 | 0 | 0 | 0 | 1 | 1 | 0 | 2 | 4 | 0 | 3 | 0 | 0 | 0 | 0 | 0 | 0 | – | – | – | – | – | – |
| Cell Periphery | 4 | 4 | 1 | 0 | 0 | 0 | 3 | 1 | 5 | 1 | 5 | 3 | 4 | 0 | 1 | 7 | 8 | 4 | 0 | 0 | 0 | 0 | 0 | 0 |
| Cytoplasm | 246 | 249 | 230 | 228 | 247 | 396 | 392 | 481 | 304 | 408 | 290 | 431 | 261 | 317 | 349 | 135 | 132 | 94 | 228 | 240 | 233 | 121 | 170 | 225 |
| Endoplasmic Reticulum | 0 | 1 | 1 | 0 | 0 | 1 | 1 | 0 | 8 | 0 | 1 | 2 | 1 | 3 | 3 | 5 | 2 | 4 | 0 | 0 | 1 | 3 | 3 | 3 |
| Endosome | 1 | 0 | 0 | 1 | 0 | 2 | 0 | 1 | 0 | 3 | 1 | 2 | 0 | 1 | 0 | 0 | 0 | 0 | 4 | 1 | 2 | 1 | 2 | 2 |
| Golgi | 1 | 0 | 0 | 0 | 0 | 0 | 0 | 0 | 0 | 0 | 0 | 0 | 0 | 0 | 0 | 0 | 0 | 0 | 3 | 1 | 0 | 2 | 1 | 1 |
| Mitochondria | 8 | 1 | 14 | 24 | 45 | 150 | 250 | 298 | 289 | 275 | 237 | 345 | 0 | 0 | 0 | 2 | 2 | 1 | 7 | 3 | 10 | 5 | 7 | 9 |
| Nucleus | 1 | 1 | 0 | 0 | 2 | 1 | 2 | 6 | 2 | 4 | 2 | 1 | 0 | 0 | 1 | 0 | 1 | 0 | 0 | 1 | 0 | 0 | 0 | 1 |
| Nuclear Periphery | 0 | 0 | 1 | 0 | 1 | 0 | 2 | 1 | 5 | 2 | 1 | 2 | 0 | 0 | 0 | 0 | 0 | 0 | 0 | 0 | 0 | 0 | 0 | 0 |
| Nucleolus | 1 | 0 | 0 | 0 | 1 | 0 | 0 | 1 | 0 | 4 | 0 | 0 | 0 | 0 | 0 | 0 | 0 | 0 | 0 | 0 | 0 | 0 | 0 | 0 |
| Peroxisomes | 0 | 0 | 0 | 0 | 0 | 0 | 0 | 0 | 0 | 0 | 0 | 0 | 0 | 0 | 0 | 0 | 0 | 0 | 0 | 0 | 0 | 0 | 0 | 0 |
| SpindlePole | 0 | 0 | 0 | 0 | 0 | 1 | 1 | 3 | 2 | 2 | 2 | 3 | 0 | 0 | 0 | 0 | 0 | 0 | 0 | 0 | 0 | 0 | 4 | 1 |
| Vac/Vac Membrane | 1 | 0 | 0 | 0 | 2 | 2 | 3 | 6 | 3 | 11 | 7 | 6 | 0 | 0 | 0 | 0 | 0 | 0 | 1 | 2 | 9 | 9 | 8 | 11 |
| Unique Cell Count | 257 | 253 | 232 | 233 | 261 | 477 | 521 | 657 | 494 | 587 | 424 | 634 | 261 | 320 | 352 | 136 | 133 | 95 | 254 | 261 | 269 | 148 | 210 | 266 |
| Labelled Cell Count | 263 | 258 | 249 | 253 | 302 | 563 | 664 | 815 | 628 | 721 | 568 | 818 | 266 | 322 | 354 | 149 | 145 | 103 | 254 | 261 | 269 | 148 | 210 | 266 |
Yeast GFP Assignment
Protein Abundance
| Screen | WT1 | WT2 | WT3 | RAP60 | RAP140 | RAP220 | RAP300 | RAP380 | RAP460 | RAP540 | RAP620 | RAP700 | HU80 | HU120 | HU160 | rpd3Δ_1 | rpd3Δ_2 | rpd3Δ_3 | AF100 | AF140 | AF180 |
|---|---|---|---|---|---|---|---|---|---|---|---|---|---|---|---|---|---|---|---|---|---|
| Mean Cell GFP Intensity (1e-4) | 4.8 | 5.4 | 3.9 | 4.1 | 3.9 | 3.7 | 3.4 | 3.4 | 3.1 | 3.4 | 3.4 | 3.4 | 6.2 | 5.8 | 5.9 | 6.2 | 6.7 | 6.6 | 7.1 | 6.7 | 6.6 |
| Std Deviation (1e-4) | 0.8 | 0.8 | 0.6 | 1.8 | 1.8 | 1.0 | 1.5 | 1.1 | 0.6 | 0.8 | 0.9 | 0.9 | 1.6 | 1.3 | 1.3 | 0.9 | 1.0 | 0.9 | 2.9 | 2.2 | 1.8 |
| Intensity Change (Log2) | – | – | – | 0.08 | 0.01 | -0.08 | -0.21 | -0.21 | -0.32 | -0.21 | -0.2 | -0.18 | 0.66 | 0.56 | 0.6 | 0.66 | 0.77 | 0.76 | 0.86 | 0.78 | 0.76 |
Localization Change
| Localization | RAP60 | RAP140 | RAP220 | RAP300 | RAP380 | RAP460 | RAP540 | RAP620 | RAP700 | HU80 | HU120 | HU160 | rpd3Δ_1 | rpd3Δ_2 | rpd3Δ_3 |
|---|---|---|---|---|---|---|---|---|---|---|---|---|---|---|---|
| Cortical Patches | 0 | 0 | 0 | 0 | 0 | 0 | 0 | 0 | 0 | 0 | 0 | 0 | 0 | 0 | 0 |
| Bud | 0 | 0 | 0 | 0 | 0 | 0 | 0 | 0 | 0 | 0 | 0 | 0 | 0 | 0 | 0 |
| Bud Neck | 0 | 0 | 0 | 0 | 0 | 0 | 0 | 0 | 0 | 0 | 0 | 0 | 0 | 0 | 0 |
| Bud Site | 0 | 0 | 0 | 0 | 0 | 0 | 0 | 0 | 0 | 0 | 0 | 0 | 0 | 0 | 0 |
| Cell Periphery | 0 | 0 | 0 | 0 | 0 | 0 | 0 | 0 | 0 | 0 | 0 | 0 | 0 | 0 | 0 |
| Cytoplasm | -1.1 | -2.8 | -6.3 | -8.0 | -8.5 | -10.7 | -9.2 | -9.3 | -9.6 | 1.5 | -0.1 | 0 | 0.1 | 0.1 | -0.2 |
| Endoplasmic Reticulum | 0 | 0 | 0 | 0 | 0 | 0 | 0 | 0 | 0 | 0 | 0 | 0 | 0 | 0 | 0 |
| Endosome | 0 | 0 | 0 | 0 | 0 | 0 | 0 | 0 | 0 | 0 | 0 | 0 | 0 | 0 | 0 |
| Golgi | 0 | 0 | 0 | 0 | 0 | 0 | 0 | 0 | 0 | 0 | 0 | 0 | 0 | 0 | 0 |
| Mitochondria | 0 | 0 | 0 | 0 | 0 | 0 | 0 | 0 | 0 | -4.0 | -4.5 | -4.7 | -2.1 | -2.0 | 0 |
| Nucleus | 0 | 0 | 0 | 0 | 0 | 0 | 0 | 0 | 0 | 0 | 0 | 0 | 0 | 0 | 0 |
| Nuclear Periphery | 0 | 0 | 0 | 0 | 0 | 0 | 0 | 0 | 0 | 0 | 0 | 0 | 0 | 0 | 0 |
| Nucleolus | 0 | 0 | 0 | 0 | 0 | 0 | 0 | 0 | 0 | 0 | 0 | 0 | 0 | 0 | 0 |
| Peroxisomes | 0 | 0 | 0 | 0 | 0 | 0 | 0 | 0 | 0 | 0 | 0 | 0 | 0 | 0 | 0 |
| SpindlePole | 0 | 0 | 0 | 0 | 0 | 0 | 0 | 0 | 0 | 0 | 0 | 0 | 0 | 0 | 0 |
| Vacuole | 0 | 0 | 0 | 0 | 0 | 0 | 0 | 0 | 0 | 0 | 0 | 0 | 0 | 0 | 0 |
External localization resources
Images






























Protein Concentration and Protein Localization Data
| R1 | R2 | R3 | ||||||||||||||||
|---|---|---|---|---|---|---|---|---|---|---|---|---|---|---|---|---|---|---|
| G1 Pre-START | G1 Post-START | S/G2 | Metaphase | Anaphase | Telophase | G1 Pre-START | G1 Post-START | S/G2 | Metaphase | Anaphase | Telophase | G1 Pre-START | G1 Post-START | S/G2 | Metaphase | Anaphase | Telophase | |
| Concentration | 0.8272 | 1.4951 | 1.1239 | 0.5554 | 1.0838 | 1.3284 | 1.7606 | 2.6715 | 2.3004 | 2.0746 | 1.6091 | 2.313 | -0.3423 | 0.1976 | -0.1534 | 0.4525 | -0.973 | -0.2314 |
| Actin | 0.0061 | 0.0053 | 0.0047 | 0.0405 | 0.0238 | 0.0016 | 0.0154 | 0.0012 | 0.0027 | 0.0003 | 0.0006 | 0.0026 | 0.0298 | 0.0011 | 0.0197 | 0.0002 | 0.0001 | 0.0006 |
| Bud | 0.0003 | 0.0041 | 0.0022 | 0.0013 | 0.0009 | 0.0006 | 0.0003 | 0.0006 | 0.0008 | 0.0002 | 0.0001 | 0.0002 | 0.0003 | 0.0003 | 0.0032 | 0.0001 | 0.0001 | 0.0001 |
| Bud Neck | 0.0012 | 0.0005 | 0.0011 | 0.0016 | 0.0003 | 0.0013 | 0.0024 | 0.0001 | 0.0002 | 0.0002 | 0.0002 | 0.0006 | 0.0002 | 0.0002 | 0.0002 | 0.0001 | 0.0001 | 0.0003 |
| Bud Periphery | 0.0003 | 0.0014 | 0.0042 | 0.0015 | 0.002 | 0.0008 | 0.0003 | 0.0006 | 0.0011 | 0.0001 | 0.0001 | 0.0001 | 0.0004 | 0.0002 | 0.0041 | 0 | 0.0001 | 0.0002 |
| Bud Site | 0.0027 | 0.0149 | 0.0034 | 0.0176 | 0.0007 | 0.0001 | 0.0012 | 0.0008 | 0.0013 | 0.0002 | 0.0002 | 0 | 0.0017 | 0.002 | 0.0137 | 0.0001 | 0 | 0.0003 |
| Cell Periphery | 0.0003 | 0.0003 | 0.0004 | 0.0001 | 0.0002 | 0.0001 | 0.0003 | 0.0002 | 0.0002 | 0.0002 | 0.0001 | 0 | 0.0002 | 0.0002 | 0.0004 | 0 | 0 | 0 |
| Cytoplasm | 0.3398 | 0.4696 | 0.3764 | 0.2984 | 0.3104 | 0.451 | 0.3914 | 0.4969 | 0.4959 | 0.5791 | 0.5126 | 0.5219 | 0.2308 | 0.5961 | 0.5621 | 0.6661 | 0.8546 | 0.69 |
| Cytoplasmic Foci | 0.0207 | 0.0096 | 0.0124 | 0.0385 | 0.0092 | 0.0092 | 0.0096 | 0.0057 | 0.0153 | 0.0167 | 0.0226 | 0.0107 | 0.0592 | 0.0054 | 0.0088 | 0.0194 | 0.0037 | 0.0116 |
| Eisosomes | 0.0001 | 0.0001 | 0.0002 | 0.0012 | 0.0004 | 0.0001 | 0.0002 | 0.0001 | 0.0001 | 0 | 0.0001 | 0.0001 | 0.0003 | 0.0001 | 0.0001 | 0 | 0 | 0 |
| Endoplasmic Reticulum | 0.0034 | 0.0019 | 0.004 | 0.0014 | 0.0037 | 0.0014 | 0.0033 | 0.0017 | 0.0011 | 0.0013 | 0.0034 | 0.0007 | 0.0052 | 0.0016 | 0.002 | 0.0019 | 0.0017 | 0.0012 |
| Endosome | 0.0057 | 0.0028 | 0.0033 | 0.0062 | 0.011 | 0.0023 | 0.0044 | 0.0023 | 0.0058 | 0.0037 | 0.0051 | 0.0022 | 0.0497 | 0.0068 | 0.0077 | 0.0147 | 0.0025 | 0.0082 |
| Golgi | 0.0014 | 0.0005 | 0.0009 | 0.0023 | 0.0023 | 0.0002 | 0.0013 | 0.0002 | 0.0004 | 0.0003 | 0.0005 | 0.0004 | 0.0158 | 0.0053 | 0.0085 | 0.0003 | 0.0001 | 0.0038 |
| Lipid Particles | 0.0022 | 0.0003 | 0.001 | 0.0029 | 0.0014 | 0.0002 | 0.0014 | 0.0001 | 0.0004 | 0.0001 | 0.0006 | 0.0006 | 0.0473 | 0.0002 | 0.0015 | 0 | 0 | 0.0012 |
| Mitochondria | 0.0008 | 0.0005 | 0.001 | 0.0031 | 0.0033 | 0.0004 | 0.0005 | 0.0002 | 0.0007 | 0.0003 | 0.0004 | 0.0002 | 0.0059 | 0.0047 | 0.0284 | 0.0001 | 0.0001 | 0.0352 |
| None | 0.603 | 0.4826 | 0.5722 | 0.5586 | 0.6157 | 0.5269 | 0.5587 | 0.4867 | 0.4691 | 0.3951 | 0.4491 | 0.4558 | 0.5179 | 0.3733 | 0.3323 | 0.2936 | 0.1337 | 0.2425 |
| Nuclear Periphery | 0.0014 | 0.0005 | 0.0014 | 0.002 | 0.0075 | 0.0005 | 0.0017 | 0.0003 | 0.0006 | 0.0003 | 0.0009 | 0.0009 | 0.0023 | 0.0003 | 0.0005 | 0.0005 | 0.0005 | 0.0003 |
| Nucleolus | 0.0005 | 0.0003 | 0.0006 | 0.0009 | 0.0003 | 0.0002 | 0.0004 | 0.0001 | 0.0001 | 0 | 0.0001 | 0.0001 | 0.0002 | 0.0001 | 0.0001 | 0 | 0 | 0 |
| Nucleus | 0.0013 | 0.0018 | 0.0036 | 0.0038 | 0.0016 | 0.0013 | 0.0011 | 0.0007 | 0.001 | 0.0005 | 0.0009 | 0.0008 | 0.0006 | 0.0004 | 0.0007 | 0.0006 | 0.0006 | 0.0018 |
| Peroxisomes | 0.003 | 0.0004 | 0.0016 | 0.0057 | 0.0011 | 0.0003 | 0.0012 | 0.0001 | 0.0007 | 0.0004 | 0.0006 | 0.0003 | 0.0241 | 0.0002 | 0.0018 | 0 | 0 | 0.0006 |
| Punctate Nuclear | 0.0047 | 0.0015 | 0.0024 | 0.0107 | 0.0014 | 0.0009 | 0.0019 | 0.0002 | 0.0011 | 0.0003 | 0.0011 | 0.0011 | 0.0037 | 0.0002 | 0.0003 | 0.0002 | 0.0001 | 0.0001 |
| Vacuole | 0.0011 | 0.001 | 0.0025 | 0.0013 | 0.0013 | 0.0006 | 0.0025 | 0.0011 | 0.0012 | 0.0006 | 0.0007 | 0.0005 | 0.0033 | 0.001 | 0.0032 | 0.0017 | 0.0017 | 0.0011 |
| Vacuole Periphery | 0.0002 | 0.0001 | 0.0004 | 0.0003 | 0.0013 | 0.0001 | 0.0002 | 0.0001 | 0.0002 | 0.0001 | 0.0001 | 0.0001 | 0.001 | 0.0002 | 0.0006 | 0.0003 | 0.0003 | 0.0007 |
Sequencing Data
| R1 | R2 | |||||||||
|---|---|---|---|---|---|---|---|---|---|---|
| G1 Post-START | S/G2 | Metaphase | Anaphase | Telophase | G1 Post-START | S/G2 | Metaphase | Anaphase | Telophase | |
| Gene Expression | 11.8995 | 12.5715 | 7.1758 | 7.1433 | 6.3115 | 12.974 | 12.4665 | 13.8585 | 13.6068 | 14.033 |
| Translational Efficiency | 0.801 | 0.526 | 0.9151 | 0.7812 | 1.029 | 0.6078 | 0.5358 | 0.3391 | 0.4634 | 0.5963 |
Hit Data
| Dataset | Hit |
|---|---|
| Protein Concentration | ✘ |
| Protein Localization | ✘ |
| Gene Expression | ✘ |
| Translational Efficiency | ✘ |
Micrographs
































Cell Count
| R1 | R2 | R1 & R2 | |||||||||
|---|---|---|---|---|---|---|---|---|---|---|---|
| WT | UBP2 | UBP14 | UBP2UBP14 | WT | UBP2 | UBP14 | UBP2UBP14 | WT | UBP2 | UBP14 | UBP2UBP14 |
| 1576 | 1203 | 463 | 97 | 1447 | 1354 | 1081 | 1366 | 3023 | 2557 | 1544 | 1463 |
Protein Abundance
| R1 | R2 | R1 & R2 | ||||||||||
|---|---|---|---|---|---|---|---|---|---|---|---|---|
| WT | UBP2 | UBP14 | UBP2UBP14 | WT | UBP2 | UBP14 | UBP2UBP14 | WT | UBP2 | UBP14 | UBP2UBP14 | |
| Mean | 691.87 | 734.96 | 921.49 | 1006.53 | 706.89 | 730.24 | 950.38 | 920.75 | 699.06 | 732.46 | 941.72 | 926.44 |
| Standard Deviation | 81.10 | 102.09 | 120.70 | 104.48 | 76.90 | 105.06 | 110.88 | 125.68 | 79.47 | 103.70 | 114.68 | 126.21 |
| Intensity Change Log 2 | — | 0.087165 | 0.413468 | 0.540817 | — | 0.046885 | 0.427019 | 0.381324 | — | 0.066949 | 0.420332 | 0.462418 |
Localization Score (DeepLoc)
| R1 | R2 | R1 & R2 | ||||||||||
|---|---|---|---|---|---|---|---|---|---|---|---|---|
| WT | UBP2 | UBP14 | UBP2UBP14 | WT | UBP2 | UBP14 | UBP2UBP14 | WT | UBP2 | UBP14 | UBP2UBP14 | |
| Actin | 0.000112 | 0.000338 | 0.000269 | 0.000401 | 0.000097 | 0.000518 | 0.000274 | 0.001351 | 0.000105 | 0.000433 | 0.000273 | 0.001288 |
| Bud Neck | 0.013350 | 0.029025 | 0.001576 | 0.018536 | 0.010491 | 0.040899 | 0.001810 | 0.001603 | 0.011982 | 0.035312 | 0.001740 | 0.002726 |
| Bud Site | 0.005949 | 0.018205 | 0.003800 | 0.056981 | 0.004794 | 0.024680 | 0.006131 | 0.011185 | 0.005396 | 0.021634 | 0.005432 | 0.014221 |
| Cell Periphery | 0.000084 | 0.000105 | 0.000111 | 0.000188 | 0.000107 | 0.000170 | 0.000071 | 0.000077 | 0.000095 | 0.000139 | 0.000083 | 0.000084 |
| Cytoplasm | 0.549299* | 0.456559* | 0.634125* | 0.403611* | 0.571185* | 0.408818* | 0.701446* | 0.696578* | 0.559775* | 0.431279* | 0.681258* | 0.677154* |
| Cytoplasmic Foci | 0.223148* | 0.247093* | 0.013379 | 0.053779 | 0.227414* | 0.278939* | 0.025452 | 0.032419 | 0.225190* | 0.263956* | 0.021832 | 0.033835 |
| Eisosomes | 0.000116 | 0.000111 | 0.000030 | 0.000088 | 0.000093 | 0.000200 | 0.000029 | 0.000031 | 0.000105 | 0.000158 | 0.000029 | 0.000035 |
| Endoplasmic Reticulum | 0.000686 | 0.000860 | 0.002696 | 0.001983 | 0.001145 | 0.000695 | 0.000726 | 0.000563 | 0.000906 | 0.000772 | 0.001317 | 0.000657 |
| Endosome | 0.014820 | 0.031076 | 0.002241 | 0.013521 | 0.012068 | 0.034197 | 0.004728 | 0.002722 | 0.013503 | 0.032728 | 0.003982 | 0.003438 |
| Golgi | 0.003010 | 0.004972 | 0.000103 | 0.000215 | 0.002473 | 0.008971 | 0.000579 | 0.001442 | 0.002753 | 0.007090 | 0.000436 | 0.001360 |
| Lipid Particles | 0.006468 | 0.005456 | 0.001135 | 0.003500 | 0.005397 | 0.006941 | 0.000943 | 0.000657 | 0.005955 | 0.006243 | 0.001001 | 0.000846 |
| Mitochondria | 0.002836 | 0.007817 | 0.000171 | 0.000323 | 0.002577 | 0.014113 | 0.000290 | 0.001037 | 0.002712 | 0.011151 | 0.000255 | 0.000990 |
| Mitotic Spindle | 0.000476 | 0.005380 | 0.000739 | 0.012679 | 0.000849 | 0.011410 | 0.003489 | 0.003050 | 0.000654 | 0.008573 | 0.002664 | 0.003688 |
| None | 0.002432 | 0.002628 | 0.004712 | 0.000852 | 0.002245 | 0.001159 | 0.003249 | 0.005438 | 0.002343 | 0.001850 | 0.003688 | 0.005133 |
| Nuclear Periphery | 0.000278 | 0.000338 | 0.000842 | 0.000625 | 0.000278 | 0.000267 | 0.000521 | 0.000331 | 0.000278 | 0.000301 | 0.000617 | 0.000351 |
| Nuclear Periphery Foci | 0.000305 | 0.000577 | 0.003213 | 0.008445 | 0.000615 | 0.000385 | 0.001739 | 0.001198 | 0.000453 | 0.000476 | 0.002181 | 0.001678 |
| Nucleolus | 0.000778 | 0.001516 | 0.000195 | 0.000167 | 0.000691 | 0.001441 | 0.000185 | 0.000214 | 0.000736 | 0.001476 | 0.000188 | 0.000211 |
| Nucleus | 0.101031 | 0.073062 | 0.250296* | 0.035261 | 0.095994 | 0.062310 | 0.101659 | 0.115555 | 0.098620 | 0.067369 | 0.146231* | 0.110231 |
| Peroxisomes | 0.002815 | 0.010857 | 0.000147 | 0.000719 | 0.002306 | 0.018081 | 0.000355 | 0.001460 | 0.002572 | 0.014682 | 0.000292 | 0.001411 |
| Vacuole | 0.070758 | 0.100966 | 0.080087 | 0.387603* | 0.058139 | 0.083339 | 0.146019 | 0.122732 | 0.064718 | 0.091632 | 0.126248 | 0.140294 |
| Vacuole Periphery | 0.001249 | 0.003058 | 0.000132 | 0.000522 | 0.001043 | 0.002468 | 0.000305 | 0.000358 | 0.001150 | 0.002746 | 0.000253 | 0.000369 |
Localization Changes (T-score)
| R1 | R2 | R1 & R2 | |||||||||||||
|---|---|---|---|---|---|---|---|---|---|---|---|---|---|---|---|
| UBP2_WT | UBP14_WT | UBP2UBP14_WT | UBP2UBP14_UBP2 | UBP2UBP14_UBP14 | UBP2_WT | UBP14_WT | UBP2UBP14_WT | UBP2UBP14_UBP2 | UBP2UBP14_UBP14 | UBP2_WT | UBP14_WT | UBP2UBP14_WT | UBP2UBP14_UBP2 | UBP2UBP14_UBP14 | |
| Actin | -5.83 | -6.34 | -4.30 | -0.80 | -0.72 | -8.97 | -1.23 | -1.55 | -0.65 | -1.28 | -10.52 | -2.19 | -1.58 | -0.82 | -1.23 |
| Bud Neck | -6.64 | 11.79 | 2.05 | 5.75 | -1.46 | -10.89 | 6.92 | 8.58 | 15.10 | 0.78 | -12.62 | 12.11 | 13.88 | 19.30 | 0.19 |
| Bud Site | -7.03 | 1.59 | -1.85 | -0.69 | -2.03 | -10.56 | -0.46 | -2.48 | 6.56 | -1.92 | -12.51 | 0.53 | -2.72 | 5.69 | -2.82 |
| Cell Periphery | -2.94 | -4.14 | -2.34 | -1.24 | -0.38 | -4.69 | 7.23 | 7.18 | 7.91 | -0.78 | -5.65 | 2.70 | 5.54 | 8.50 | 2.13 |
| Cytoplasm | 8.92 | -0.26 | 7.49 | 4.12 | 7.22 | 15.80 | -4.68 | -5.62 | -20.51 | -0.55 | 17.52 | -4.92 | -5.48 | -19.14 | -0.71 |
| Cytoplasmic Foci | -2.83 | 40.03 | 24.92 | 25.80 | -4.26 | -6.23 | 37.28 | 35.60 | 39.41 | -4.42 | -6.62 | 53.85 | 49.47 | 51.51 | -6.91 |
| Eisosomes | 0.55 | 8.48 | 3.06 | 3.11 | -5.61 | -8.09 | 15.09 | 14.83 | 13.01 | -1.06 | -6.09 | 14.30 | 13.78 | 16.34 | -1.45 |
| Endoplasmic Reticulum | -1.53 | -7.97 | -3.60 | -3.26 | 1.41 | 1.86 | 0.86 | 1.96 | -0.06 | 3.67 | 1.00 | -5.00 | 0.60 | -0.69 | 7.08 |
| Endosome | -7.90 | 12.46 | 2.91 | 8.44 | -3.03 | -10.97 | 9.31 | 12.36 | 17.30 | 2.63 | -13.31 | 14.46 | 16.76 | 22.99 | 1.77 |
| Golgi | -3.14 | 10.10 | 9.71 | 8.98 | -2.28 | -6.95 | 6.49 | 2.64 | 7.66 | -0.78 | -7.52 | 10.35 | 3.46 | 8.24 | -0.90 |
| Lipid Particles | 1.27 | 7.53 | 5.30 | 4.73 | -3.04 | -2.12 | 10.64 | 11.37 | 10.46 | 2.15 | -0.48 | 12.22 | 13.03 | 13.69 | 2.80 |
| Mitochondria | -3.59 | 6.13 | 6.12 | 5.88 | 0.27 | -6.53 | 3.55 | 2.65 | 8.11 | -1.14 | -7.43 | 6.38 | 4.26 | 9.55 | -1.18 |
| Mitotic Spindle | -3.81 | -2.31 | -2.13 | -1.12 | -1.98 | -4.61 | -2.65 | -2.80 | 3.51 | -0.18 | -5.84 | -3.30 | -3.82 | 3.24 | -1.37 |
| None | -0.35 | -3.57 | 5.65 | 2.75 | 8.63 | 4.19 | -2.62 | -4.11 | -6.30 | -2.27 | 1.20 | -3.80 | -3.76 | -4.02 | -1.54 |
| Nuclear Periphery | -1.55 | -13.13 | -4.12 | -3.84 | 0.03 | 0.20 | -12.78 | -6.61 | -6.32 | 7.84 | -0.97 | -17.58 | -7.93 | -7.33 | 9.79 |
| Nuclear Periphery Foci | -3.58 | -9.81 | -4.44 | -4.30 | -2.39 | 2.61 | -7.90 | -6.83 | -8.29 | 2.30 | -0.79 | -12.91 | -8.57 | -8.17 | 2.67 |
| Nucleolus | -2.20 | 6.88 | 2.27 | 2.92 | -0.72 | -1.70 | 6.10 | 7.90 | 2.82 | 0.21 | -2.74 | 8.43 | 9.79 | 4.34 | 0.07 |
| Nucleus | 6.09 | -16.00 | 7.29 | 3.08 | 18.51 | 7.98 | -4.93 | -5.52 | -12.74 | -0.07 | 10.06 | -13.29 | -4.71 | -12.14 | 8.29 |
| Peroxisomes | -8.05 | 14.10 | 4.21 | 9.35 | -1.53 | -11.82 | 9.68 | 3.29 | 12.51 | -1.69 | -14.22 | 15.78 | 4.36 | 15.08 | -1.88 |
| Vacuole | -7.46 | -8.05 | -15.39 | -14.09 | -12.30 | -6.84 | -19.93 | -20.22 | -15.21 | 1.90 | -9.86 | -20.85 | -22.31 | -17.17 | -2.62 |
| Vacuole Periphery | -3.67 | 7.86 | 6.52 | 6.01 | -1.71 | -6.99 | 8.98 | 5.98 | 10.09 | -0.14 | -6.25 | 10.61 | 6.82 | 9.59 | -0.32 |
Endocytosis
| Temp | Actin Patch (Sac6-tdTomato) | Cortical Patch (Sla1-GFP) | Late Endosome (Snf7-GFP) | Vacuole (Vph1-GFP) |
|---|---|---|---|---|
| 37℃ | ||||
| RT |
Cell Cycle Omics
CYCLoPs (Efm3-GFP)
| Gene / Allele | Actin Patch (Sac6-tdTomato) | Cortical Patch (Sla1-GFP) | Late Endosome (Snf7-GFP) | Vacuole (Sac6-tdTomato) |
|---|
| Gene | Images |
|---|
| Gene | Images |
|---|
Images are not yet available
Images are not yet available